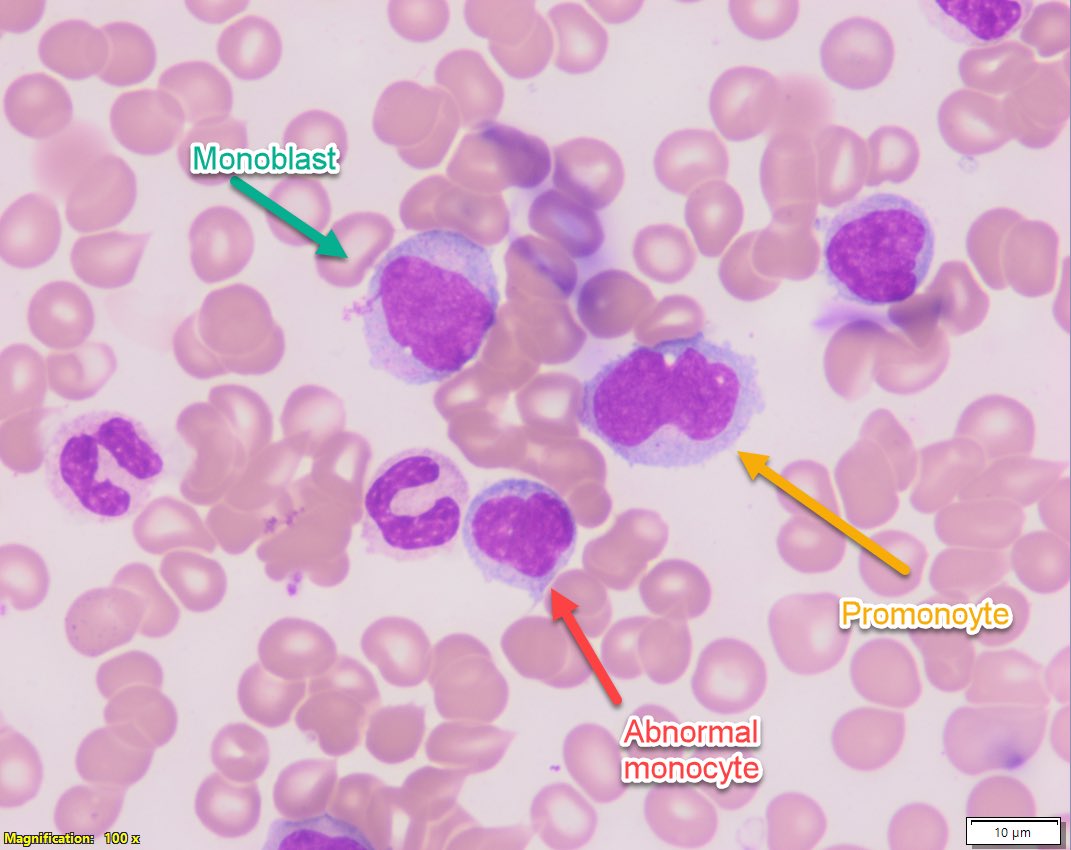
#hemepath guide 4 counting monocytes &amp; blasts in monocytic AML! Hard diffs.. even w/ experienc.
Monoblasts &amp; promonocytes R blast equivalents
Common monocytic genetics: KMT2A-r; Inv(16), RAS pathway mutations, NUP98-r, NPM1
Increased freq of venetoclax resistance
#leusm

Narendra Bhattarai
@naren_ccf
Hematopathology fellow (2023-24) @Clevelandclinic. Past AP/CP resident at Cleveland Clinic.
ID: 1070493953051557888
06-12-2018 01:43:42
594 Tweet
628 Followers
533 Following


Adrenal Gland - Endothelial (Vascular) Cyst #medtwitter #PathTwitter #pathology #Path #path2path #genitourinary #endocrine #pathoutpic PathologyOutlines.com Creighton Urology Joan Delto MD


Details to access BMU Sanam Loghavi, MD صنم لغوی 🔬🧬 + fellow Yiannis on 8-23-23 at 9:15AM CT Meeting: bit.ly/3YZ2ZvX ID: 843 3867 7292 Code: 660673 Slides: bit.ly/47FLsN2 #heme Karen Nahmod, MD PhD Siba El Hussein, MD @KirillLyapich Do Kim, M.D. Alnoor, MD النور اکبر

ALK+ anaplastic large-cell lymphoma expressing CD30 in a strong and uniform membranous and paranuclear (Golgi) pattern #hemepath #hematology #PathTwitter #pathology Cleveland Clinic Pathology Residency Genevieve Crane, MD, PhD Anna (Ania) B. Owczarczyk, MD PhD FASCP Megan Nakashima Alnoor, MD النور اکبر Siddharth Bhattacharyya, MD Daniel Babu, MD





Details to access BMU Shaoying Li, MD + fellow Roman Gonta on 8-30-23 at 9:15AM CT Meeting: bit.ly/3YRerJS ID: 833 6685 3210 Code: 643502 Slides: bit.ly/3EdOwlU #heme Karen Nahmod, MD PhD Siba El Hussein, MD @KirillLyapich Do Kim, M.D. Alnoor, MD النور اکبر







Most #Hemepath Fellowships are moving to a MATCH system for the 2025 season, including Cleveland Clinic! If you are a prospective HP fellow who is applying for positions beginning in 2026, please follow the link below for more info: society-for-hematopathology.org/web/education-…

Delighted to see this being published on pathologyoutlines.com! Genevieve Crane, MD, PhD Anna (Ania) B. Owczarczyk, MD PhD FASCP Megan Nakashima Shikha Malhotra #PathTwitter #lym